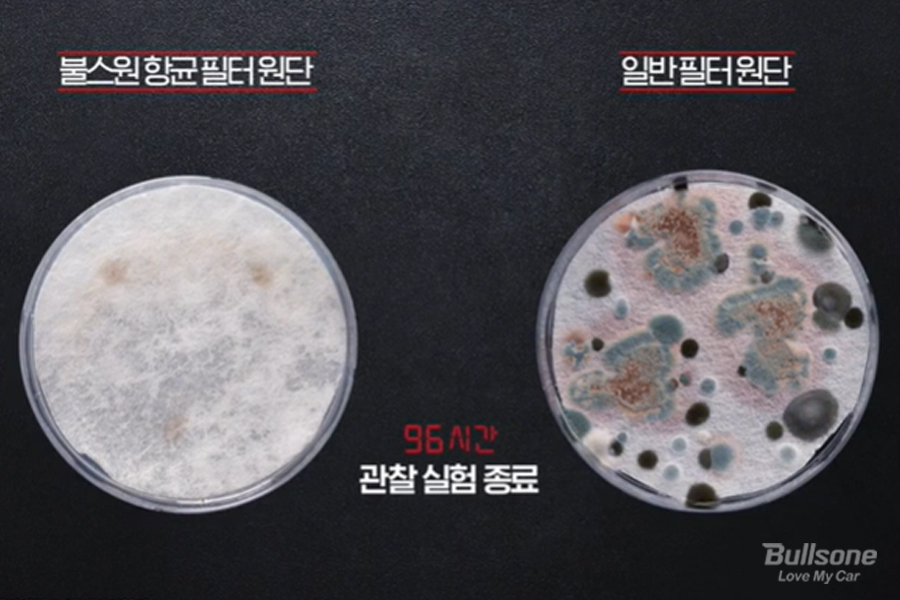
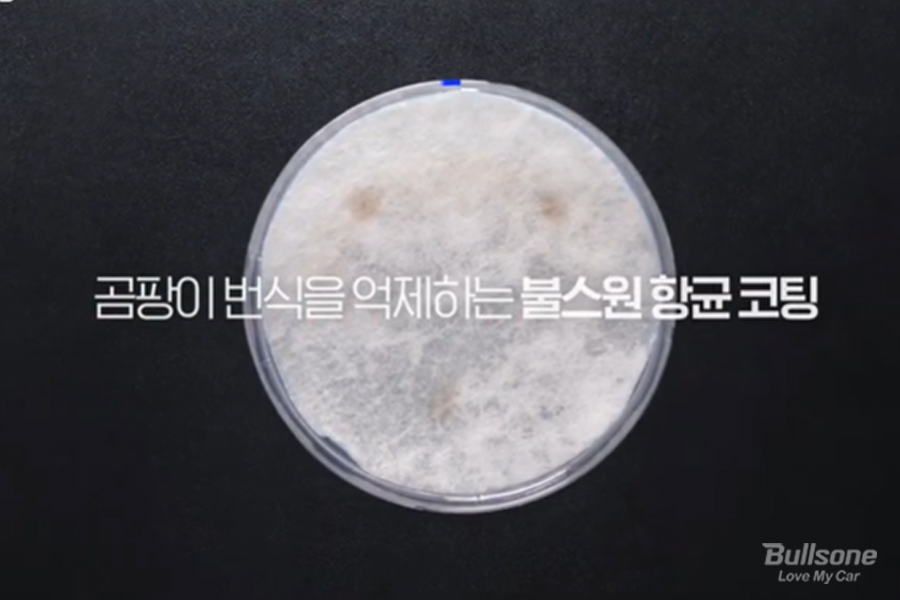

안녕하세요. 불스원입니다.
최근 들어 자동차 실내에서 발생하는 퀴퀴한 냄새 때문에 고민하시는 분들이 많습니다. 냄새를 없애기 위한 방법으로 방향·탈취제를 가장 먼저 떠올리실텐데요. 자동차 에어컨·히터 필터 관리가 되어 있지 않다면 소용 없다는 사실, 아시나요? 자동차 실내에서 발생하는 퀴퀴한 냄새의 원인은 에어컨·히터 내부의 에바포레이터 및 필터에 서식하는 곰팡이와 세균이기 때문입니다. 오늘은 쾌적한 운전 환경을 위해 자동차 항균, 탈취, 미세먼지 문제를 한 번에 해결할 방법, 함께 알아보도록 하겠습니다.

자동차 에어컨·히터 필터 작동 시 풍기는 퀴퀴한 냄새, 아이들을 키우고 있는 집이라면 더욱 신경이 쓰이실텐데요. 냄새의 원인인 세균과 곰팡이는 높은 습도, 따뜻한 온도에서 잘 서식하며, 한 번 발생하면 빠르게 번식합니다. 따라서 더운 여름철의 에어컨, 한겨울의 히터를 작동하는 과정에서 생겨난 에바포레이터의 습기 등은 곰팡이와 세균이 번식하기 최적의 환경을 만들어줍니다.
그리고 이 때 자동차 내외부를 순환하는 공기를 직접 걸러주는 에어컨·히터 필터에도 곰팡이나 세균이 달라붙게 되죠. 그렇게 되면 겨울철 자동차 히터를 작동할 때마다 필터의 곰팡이균이 사람의 입, 코 등 호흡기로 전달되어 건강을 위협할 수 있으며, 특히 면역력이 약한 사람이나 아이들에게 호흡기 질환, 아토피 피부염 등을 일으킬 수도 있습니다.

이미 차량 내에 곰팡이 냄새가 나고 있다면 당장 필터를 교체하고, 에바포레이터 안쪽까지 관리해주는 탈취훈증캔 등을 사용해 안쪽에 숨어있는 냄새의 원인을 제거하는 것이 좋습니다. 무엇보다 차량 내 곰팡이가 생기지 않도록 예방하는 것이 가장 근본적인 방법인데요. 에어컨·히터 내부의 습기가 완전히 건조될 수 있도록 시동을 끄기 5~10분 전부터 에어컨이나 히터를 미리 끄고 송풍을 시키는 것이 좋습니다. 또한 에어컨 필터를 주기적으로 교체하는 것이 가장 확실한 곰팡이 예방법입니다.
최근 불스원에서는 차 실내에서도 세균 및 곰팡이 걱정 없이 생활할 수 있는 강력한 향균 코팅 필터가 출시되었습니다. 불스원 3중 활성탄 에어컨·히터 필터는 차세대 항균 코팅 솔루션을 적용한 필터로 항균, 탈취, 미세먼지 제거 효과를 한 번에 제공하는데요. 특히 SD 차세대 항균 코팅 솔루션을 적용해 필터 내부 세균에 대한 99.9%의 강력한 항균효과 및 필터 원단 표면의 곰팡이 번식을 막아주는 항곰팡이 효과 0등급을 갖춘 항균력이 특징입니다.
불스원 차량용 에어컨 필터를 위한 항균 코팅 솔루션은 냄새제로 에어컨 히터필터, 베이킹소다 초미세먼지 필터, 프리미엄 5중 활성탄 필터 등 기존 제품에도 순차적으로 업그레이드 적용하고 있어, 언제나 차량 내 공기질을 청결하게 유지하실 수 있습니다.
지금까지 자동차 곰팡이 원인과 해결법에 대해 알아보았는데요. 자동차 실내 공기와 컨디션 관리를 위해서는 곰팡이 발생을 예방하는 것이 가장 중요하다는 것, 잊지 말아야 합니다. 자동차 곰팡이 예방을 돕는 에어컨 필터 관리를 통해 운전자와 동승자의 건강을 지켜보세요!
